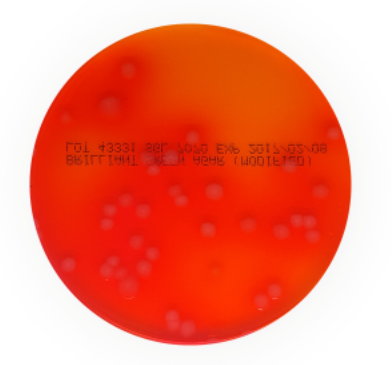

Code: SG7070
Brilliant Green Agar Medium is used for selective isolation of Salmonellae other than Salmonella Typhi from faeces,
per PK 10
Loading...
A selective medium for the isolation of salmonellae other than S. typhi